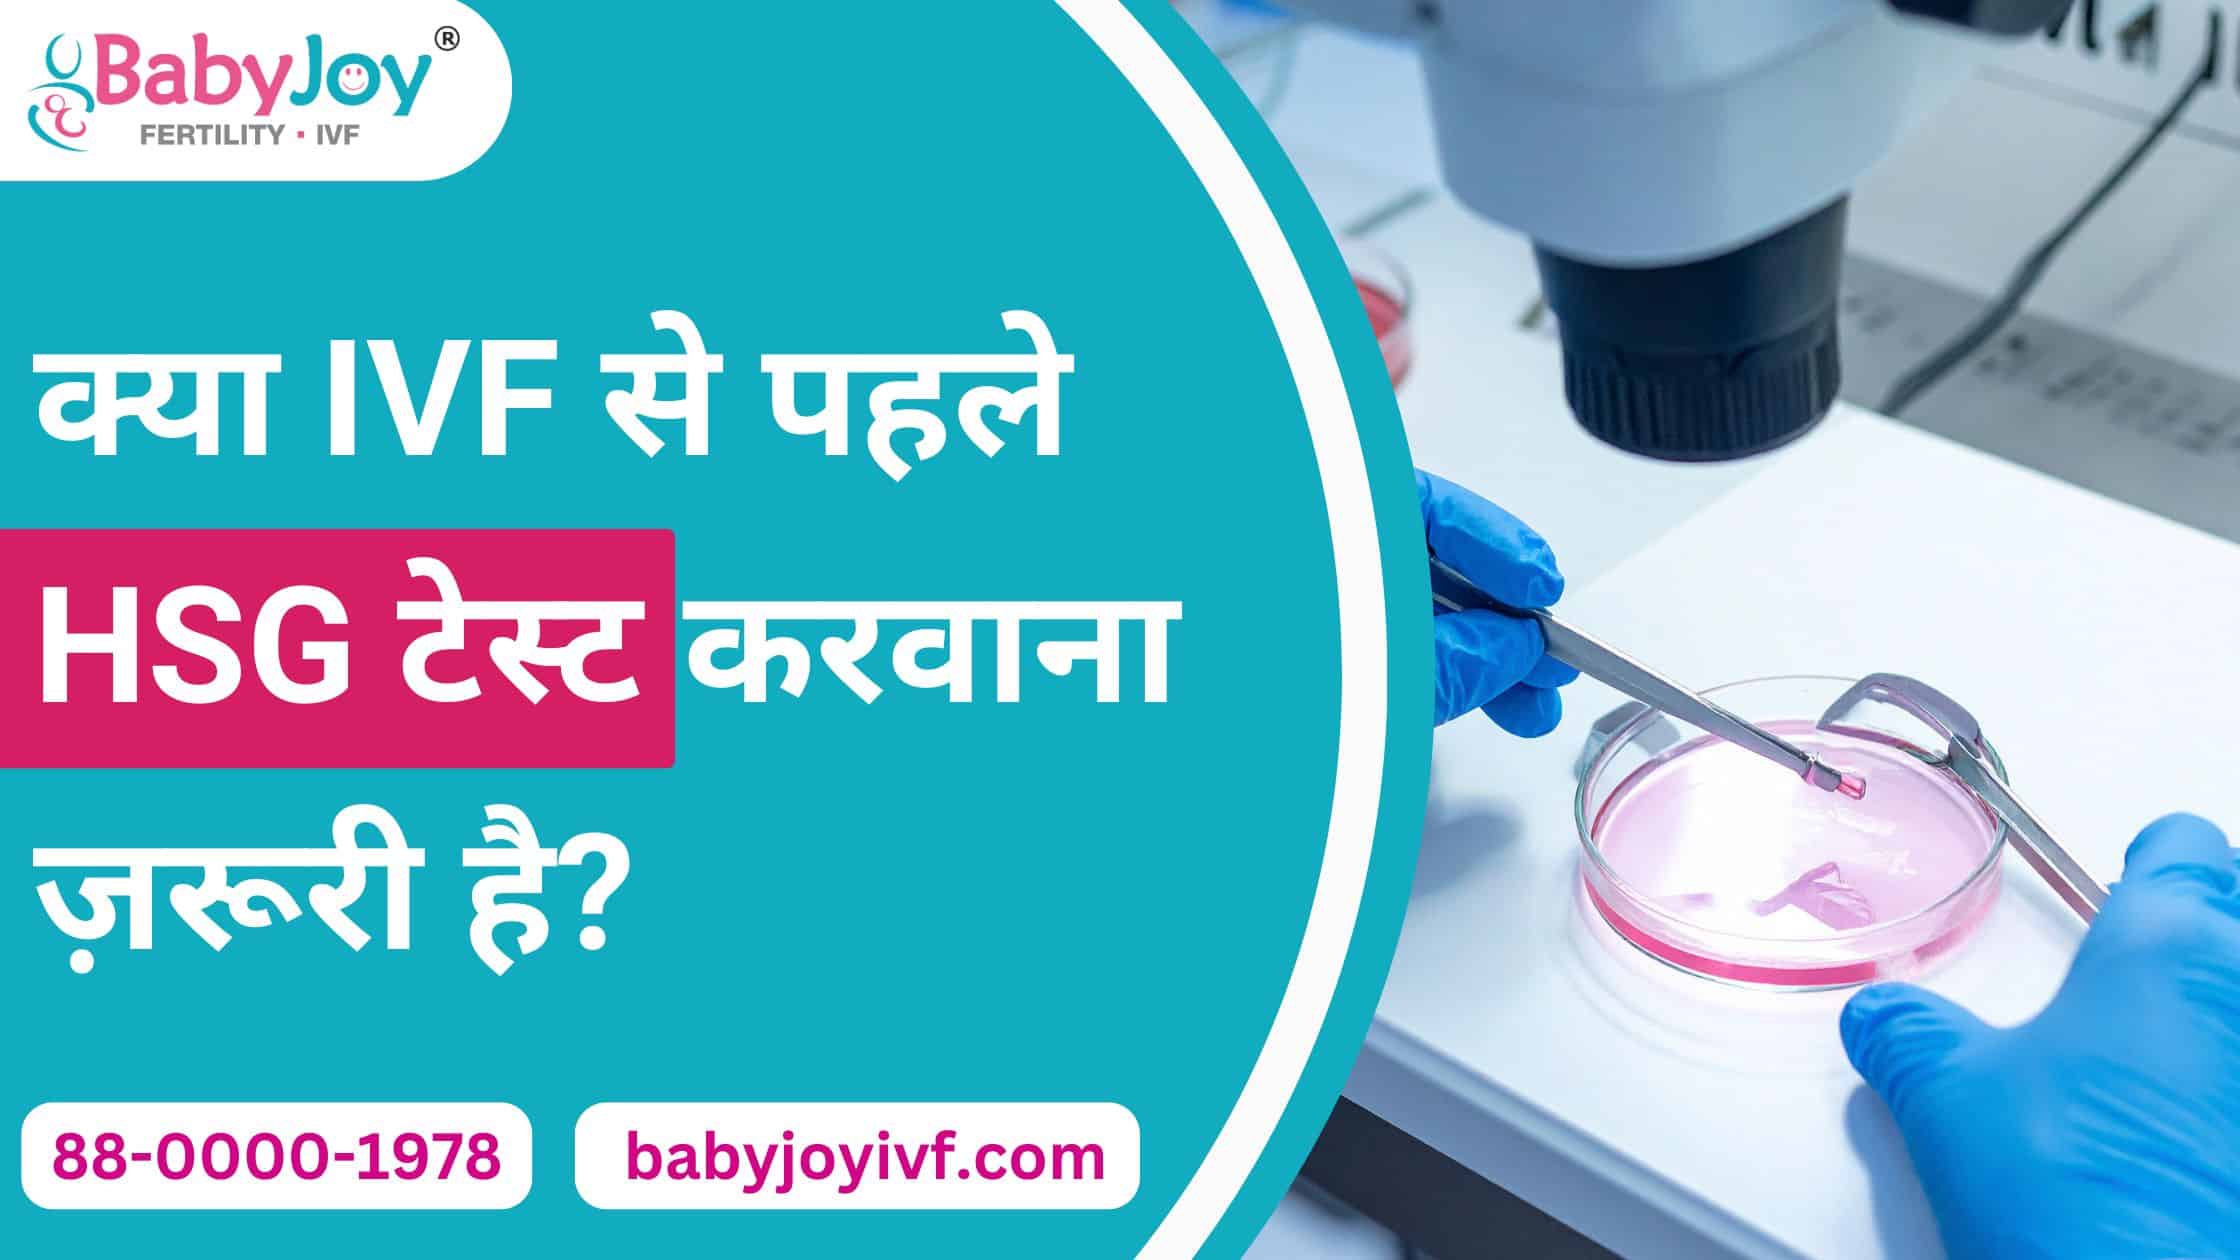
IVF Clinic in Delhi

क्या IVF से पहले HSG टेस्ट करवाना ज़रूरी है?
जब किसी कपल्स को लंबे समय तक कोशिश करने के बाद भी गर्भधारण नहीं हो पाता, तब ऐसे में डॉक्टर IVF (In Vitro Fertilization) जैसी आधुनिक तकनीक की सलाह देते हैं। IVF शुरू करने से पहले कई जांचें की जाती हैं ताकि उपचार सफल रहे इन्हीं में से एक है HSG टेस्ट (Hysterosalpingography Test)। यह जांच गर्भाशय और फैलोपियन ट्यूब्स की स्थिति का पता लगाती है और डॉक्टर को यह समझने में मदद करती है कि गर्भधारण में रुकावट कहां हो सकती है। एक अनुभवी IVF Clinic in Delhi में HSG टेस्ट को IVF प्रक्रिया की तैयारी का ज़रूरी हिस्सा माना जाता है, जिससे डॉक्टर आपके लिए सबसे सही इलाज का प्लान बना सकते हैं।
HSG टेस्ट क्या होता है?
HSG टेस्ट एक विशेष प्रकार का एक्स-रे होता है, जो महिला के गर्भाशय (Uterus) और फैलोपियन ट्यूब्स (Fallopian Tubes) की स्थिति जांचने के लिए किया जाता है। इस टेस्ट में एक डाई (Contrast Fluid) गर्भाशय में डाली जाती है, जो एक्स-रे मशीन की मदद से ट्यूब्स के अंदर बहाव दिखाती है।
- अगर डाई ट्यूब्स के अंदर से होकर आसानी से बाहर निकल जाती है, तो इसका मतलब है कि ट्यूब्स खुली (Open) हैं।
- लेकिन अगर डाई का बहाव रुक जाता है, तो इसका मतलब है कि ट्यूब्स में रुकावट (Blockage) है। अगर आपके मन में इससे जुड़े कोई भी सवाल है तो दिल्ली के अच्छे IVF क्लिनिक ( Best IVF Clinic in Delhi ) से सलाह लें
IVF से पहले HSG टेस्ट क्यों ज़रूरी है?
हालांकि IVF में अंडाणु (Egg) और शुक्राणु (Sperm) को शरीर के बाहर मिलाया जाता है, फिर भी HSG टेस्ट IVF शुरू करने से पहले कई कारणों से किया जाता है:
1. फैलोपियन ट्यूब्स की स्थिति जानने के लिए:
अगर ट्यूब्स बंद हैं, तो प्राकृतिक गर्भधारण संभव नहीं होता। ऐसे में IVF ही एकमात्र समाधान हो सकता है।
2. गर्भाशय की आकृति जांचने के लिए:
कभी-कभी गर्भाशय में फाइब्रॉइड्स, पॉलीप्स या स्ट्रक्चरल प्रॉब्लम्स होती हैं जो IVF की सफलता को प्रभावित कर सकती हैं। दिल्ली के सबसे अच्छे IVF क्लिनिक ( Top IVF Clinic in Delhi ) द्वारा करवाए गए HSG टेस्ट इन समस्याओं को पहचानने में मदद करता है।
3. संभावित संक्रमण या जलन का पता लगाने के लिए:
ट्यूब्स या गर्भाशय में पुराने संक्रमण (Infection) के निशान या सूजन (Inflammation) का पता इस टेस्ट से चल जाता है।
4. IVF प्लानिंग को बेहतर बनाने के लिए:
HSG रिपोर्ट देखने के बाद डॉक्टर तय कर सकते हैं कि IVF शुरू करने से पहले किसी उपचार या सर्जरी की आवश्यकता है या नहीं।
HSG टेस्ट कब करवाया जाता है?
ज़्यादातर यह टेस्ट मासिक धर्म समाप्त होने के 7वें से 10वें दिन के बीच किया जाता है। इस समय गर्भाशय की परत पतली होती है और गर्भधारण की संभावना नहीं होती, जिससे टेस्ट ज़्यादा सही और सुरक्षित होता है। ज़्यादा जानकारी के लिए अपने नज़दीकी दिल्ली के IVF क्लिनिक ( IVF Clinic in Delhi ) से समारक करके अपने सफर को सुरक्षित बनाएं
क्या HSG टेस्ट दर्दनाक होता है?
HSG टेस्ट के दौरान हल्का दर्द या असहजता महसूस हो सकती है, जो कुछ मिनटों में कम हो जाती है। डॉक्टर अक्सर टेस्ट से पहले हल्की दर्द निवारक दवा देते हैं ताकि आपको ज्यादा परेशानी न हो।
निष्कर्ष:
HSG टेस्ट IVF से पहले एक महत्वपूर्ण जांच है क्योंकि यह गर्भाशय और फैलोपियन ट्यूब्स की स्थिति की पूरी तस्वीर देता है। इससे डॉक्टर यह समझ पाते हैं कि समस्या कहां है और IVF के लिए क्या तैयारी करनी चाहिए। यदि आप IVF की योजना बना रही हैं, तो अपने IVF डॉक्टर से HSG टेस्ट की सलाह ज़रूर लें। सही जांच और सही समय पर किया गया IVF इलाज आपकी सफलता की संभावना को कई गुना बढ़ा सकता है। और अगर आप IVF के इलाज का प्लान बना रहे है तो आपके लिए यह जानना भी बहुत ज़रूरी है की दिल्ली में IVF की लागत ( IVF Cost in Delhi ) कितनी है, जिससे आप अपने सफर को सुरक्षित बना सकें
FAQ’s
1. HSG टेस्ट क्या होता है?
HSG (Hysterosalpingography) एक एक्स-रे आधारित टेस्ट है, जो महिला के गर्भाशय और फैलोपियन ट्यूब्स की स्थिति जांचने के लिए किया जाता है। इसमें एक विशेष डाई गर्भाशय में डाली जाती है ताकि ट्यूब्स में रुकावट या संरचनात्मक समस्या का पता चल सके।
2. क्या IVF से पहले HSG टेस्ट जरूरी है?
हाँ, ज़्यादातर मामलों में IVF से पहले HSG टेस्ट करवाना जरूरी होता है। यह टेस्ट यह बताता है कि ट्यूब्स खुली हैं या ब्लॉक, और गर्भाशय की आकृति सामान्य है या नहीं। इससे IVF का प्लान बेहतर तरीके से बनाई जा सकती है। अगर आपके मन में इससे जुड़े कोई भी सवाल है तो दिल्ली के सबसे अच्छे IVF क्लिनिक ( Top IVF Clinic in Delhi ) से सलाह लें।
3. HSG टेस्ट कब करवाया जाता है?
यह टेस्ट आमतौर पर मासिक धर्म खत्म होने के 7वें से 10वें दिन के बीच किया जाता है। इस समय गर्भाशय की परत पतली होती है, जिससे टेस्ट अधिक सटीक और सुरक्षित रहता है।
4. क्या HSG टेस्ट दर्दनाक होता है?
टेस्ट के दौरान हल्का दर्द या ऐंठन महसूस हो सकती है, लेकिन यह कुछ ही मिनटों के लिए रहता है। डॉक्टर अक्सर दर्द निवारक दवा देते हैं ताकि असहजता कम हो सके।
5. HSG टेस्ट की रिपोर्ट IVF में कैसे मदद करती है?
HSG रिपोर्ट से डॉक्टर को पता चलता है कि ट्यूब्स और गर्भाशय की स्थिति कैसी है। अगर ट्यूब्स ब्लॉक हैं या गर्भाशय में कोई समस्या है, तो दिल्ली के IVF क्लिनिक ( IVF Clinic in Delhi ) पहले उसका इलाज कर सकते हैं, जिससे IVF की सफलता दर बढ़ जाती है।


 +91-88-0000-1978
+91-88-0000-1978